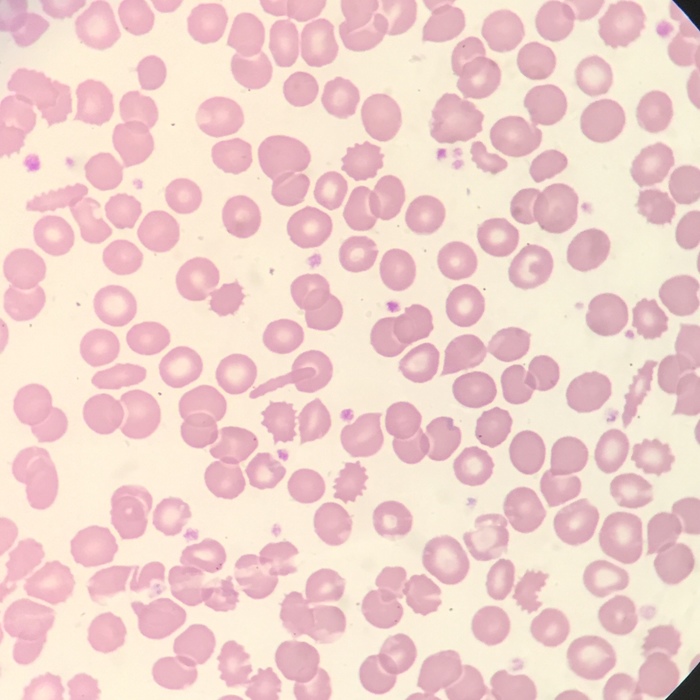
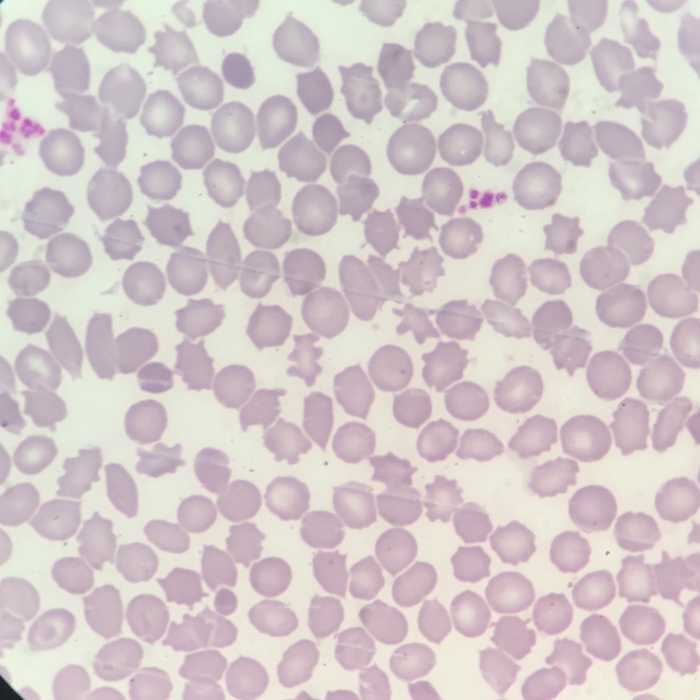
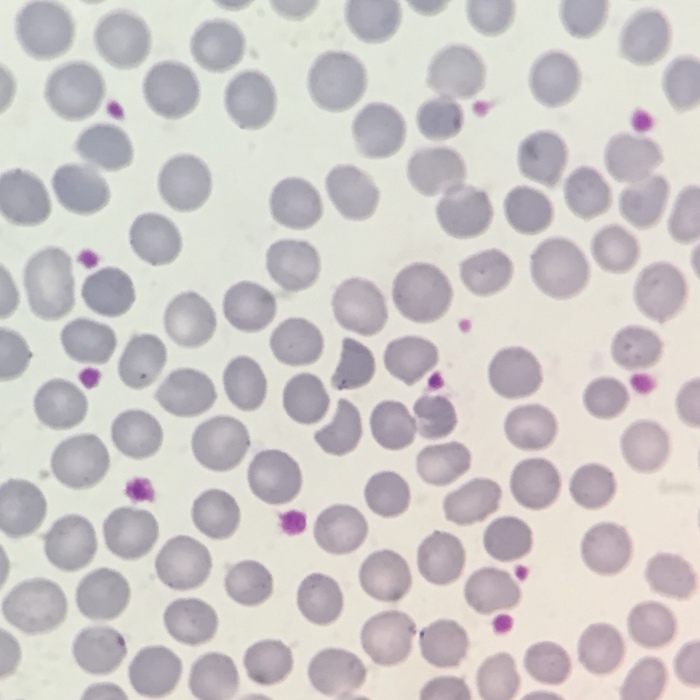
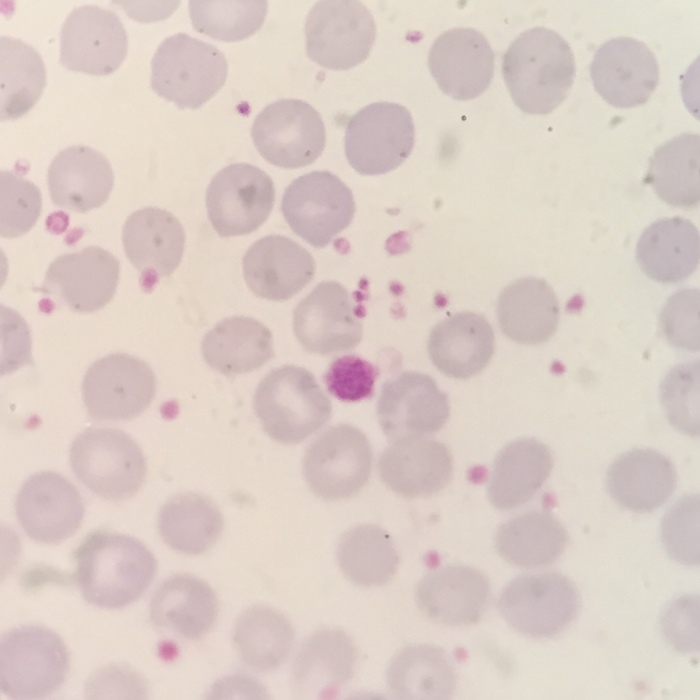

Лабораторная диагностика. Микроскопия
Дисклеймер: смотреть препараты, приготовленные из биологических жидкостей и сред человека, содержащие, порой, возбудителей и паразитов, некоторым может быть потенциально неприятно.
Итак, сегодня под объективом микроскопа вирус герпеса. Текста будет много, держитесь.
Каждый второй с тревогой следил в зеркале за разрастанием красной зудящей болячки на краю каймы губ. Каждый первый (за редким исключением) получал большой зеленый привет в детстве от ветрянки и пару недель выходных. "Редкие исключения" получали зеленые приветы уже во взрослом возрасте, и тут уже не факт, что все проходило просто и без осложнений. Очень многие сталкивались с диагнозом "инфекционный мононуклеоз" и в задумчивости морщили лбы, ища в интернете информацию, что это вообще за напасть такая. Как вы уже наверное догадались, причиной всех этих болезней является вирус герпеса. Только за каждую отвечает свой тип вируса, но об этом чуть позже. И даже если вам кажется, что "уж я-то точно ничем таким не заражался", это не значит, что вируса герпеса нет в вашем организме (да, это отсылка на пост про клеща демодекса, с которым вы может внезапно окажетесь знакомы очно).
Итак, сначала расскажу немного о разных типах вируса и что они вообще забыли в нашем организме.
1. Вирус простого герпеса (ВПГ) тип 1, оральный. Это чаще всего та самая красота, которая расцветает на губах и доставляет массу дискомфорта. ВПГ 1 есть у всех поголовно, и велик шанс того, что в ваш организм он проник от вашей мамы еще в момент родов, да-да. Возможно, у вас даже был герпес новорожденного. Но если вам повезло, и в момент родов этого не произошло, то в первые год-два жизни вы точно не избежали заражения ВПГ. Почему? Объясню чуть ниже.
2. ВПГ тип 2, генитальный. Из названия можно догадаться, что этот тип предпочитает кардинально иную локализацию - гениталии. Симптомы примерно те же, что и в типе 1. НО! Всегда есть это "но". Когда-то 1 тип вируса действительно был только оральным, но потом видимо грянула сексуальная революция и "смешались в кучу кони, люди". В том смысле, что сейчас ВПГ 1 и 2 нельзя разделить по одной конкретной локализации, оральный вполне себе может появиться на половых органах, а генитальный - наоборот на губах. А можно вообще джек пот сорвать и лечить сразу все...
Теперь вы понимаете, как и почему могли получить вирус в свой организм еще при родах. Или вскоре после рождения через поцелуи родителей. Совершенно не обязательно, что вирус сразу проявился - нет, скорее всего никаких симптомов не было. Но он затаился до времени в клетках организма.
3. Вирус ветряной оспы. Весьма контагиозная штука: если кто-то притащил из детского сада - скоро поляжет зеленой поляной вся группа. Но это даже хорошо: в детском возрасте ветрянка протекает сравнительно легко, а вот взрослый человек вполне может угодить с осложнениями в реанимацию. Принято считать, что ветряной оспой болеют только 1 раз в жизни, позже - стойкий иммунитет. Однако... (это вместо "но")). Повторная активация в организме вируса герпеса этого типа приведет к опоясывающему лишаю. У которого ограничений по количеству рецидивов особо как-то нет :)
4. Вирус Эпштейна-Барр. А вот мы дошли и до инфекционного мононуклеоза! Может, слышали о нем под названием "поцелуйная болезнь"? Тоже часто посещает детей. Этот тип вируса герпеса (всего их 8, мы скоро закончим, держитесь) имеет особую любовь к лимфатической системе, поражает именно ее. ВЭБ же является причиной страшной своей злокачественностью лимфомы Беркитта. Для нее характерны весьма заметные клетки: они содержат в цитоплазме как будто пузырики - вакуоли. Пропустить такое довольно сложно. Предвосхищая возможные вопросы: "клетка-цветочек" или "кольцо", если хотите, между этой троицы находится в митозе, поэтому так выглядит.
5. Цитомегаловирус. Страшен для беременных - активная инфекция в период беременности способна вызвать аномалии развития у плода. Но к счастью, все же встречается не так часто как ВПГ 1 и 2. ЦМВ может долго скрыто жить в организме и внезапно проявить активность при иммунодефицитных состояниях. Тогда он может послужить причиной онкологических болезней.
Кстати, ЦМВ и ВПГ 1-2 входят в список TORCH-инфекций, который хорошо знаком беременным женщинам. Инфицирование ими при родах или активация во время беременности может привести к необратимым поражениям плода.
6. Так и называется - вирус герпеса 6 типа. Характеризуется внезапным появлением специфической сыпи у детей и взрослых - розеолы. А также все вирусы герпеса тропны к нервной системе - поэтому способны вызывать различные неврологические нарушения, энцефалиты, менингиты и т д. Также вирус герпеса 6 типа связывают с развитием рассеянного склероза.
7. Скажем кратко: синдром хронической усталости. Подумайте над этим, когда будете лежать на диване.
8. Вирус герпеса 8 типа вызывает у больных терминальной стадией СПИД саркому Капоши. Это вид опухоли кожи (дермы). Если мне не изменяет память, у Фредди Меркьюри в конце жизненного пути она тоже появилась.
Ну все, с типами примерно разобрались. К 20-30 годам любой человек имеет в своем анамнезе и соответственно в организме как минимум 3-4 различных типа вируса герпеса. И чем старше - тем больше вероятность повстречаться с новым типом. Чем-то болел непосредственно сам, для чего-то является просто носителем без проявления какой-либо клинической симптоматики.
Вирусология в настоящее время весьма перспективная и интересная отрасль медицины. Пока что в ней много темных пятен (особенно для меня, врача КЛД, ага))). Хотя я во время учебы в меде искренне не любила кафедру инфекционных болезней, лекции по вирусологии и герпесу, в частности, слушала с открытым ртом.
Как вы уже поняли, самыми популярными типами вируса поражено можно сказать все взрослое население. Способы передачи - практически как угодно - контактно, воздушно-капельно, половым путем, через кровь. Почему же у кого-то герпес на губах появляется каждую осень, а у кого-то ни разу за всю жизнь?
При вторжении в организм белковые нити на поверхности вируса нужны для того, чтобы обмануть клетки и под видом "своего" через капсид (просто оболочка) отправить внутрь живой клетки свою генетическую информацию. Генетическая информация вируса встраивается в ДНК клетки и становится ее частью (часть команды, часть корабля). Все, они едины.
При каждом последующем делении ДНК и клетки пополам генетическая информация вируса тоже копируется по умолчанию. Здорово придумано, да? И выпилить вирус из ДНК клетки в настоящее время не представляется возможным (есть какие-то попытки научиться это делать, но к сожалению об успехе говорить пока рано). И то, насколько часто будет появляться условный герпес на губах - зависит от активности этого дополнительного вирусного хвоста у ДНК клетки. А любые триггерные механизмы могут способствовать этому - простыли, стресс, ослаб иммунитет и т. д. Вирус активен - нате пожалуйста вам воспаление. Вирус спит - живем спокойно.
Знаете жуткие истории из жизни некоторых животных, когда паразит, развивающийся в организме, заставляет своего хозяина вести себя нетипично? Например, лезть к хищнику, чтобы его поймали и съели. Так вот, вирус умеет примерно также: помимо того, что он встраивается в ДНК клетки, он заставляет эту самую клетку копировать свою вирусную ДНК большое количество раз (таким образом создаются новые вирусные частицы - вирионы) и отпочковывать их от наружной мембраны клетки в специальных мини-капсулах, отправляя дальше странствовать по организму и заражать его.
Фууух, после такого длинного, но важного предисловия мы наконец-то добрались до фоточек. Если не устали - читаем дальше!
Как вы уже поняли, коварство вируса заключается в поражении ДНК клетки. И когда это случается - конечно же ядро (хранилище ДНК) видоизменяется.
Все фото ниже - это женские урогенительные мазки. Какой тип герпеса - ВПГ 1 или 2 достоверно сказать не могу, да и значения на самом деле это не имеет.
Сравните ядра здоровых клеток (точечные, бордовые стрелки) и ядро клетки, пораженное вирусом. Оно невероятно огромное, сложенное, кривое и с какими-то лопастями. Да и сама клетка гигантская (голубой ореол вокруг ядра).
Вот эта клетка мне очень нравится. Называю ее "лодочка", почему-то напоминает ядром каноэ. Вирус закрутил его в спираль. Конечно, в практическом смысле толку от этой клетки организму не особо много.
Ниже еще один вариант поражения, снова гигантская клетка и ядро с несколькими лопастями. Как вы уже догадались наверное, подобные изменения ядра являются довольно характерным признаком для вирусного поражения.
Общий фон тоже довольно воспалительный и не здоровый, но на него сейчас внимания обращать не нужно. В случае обнаружения всевозможных аномалий и отклонений в мазках - об этом стоит упомянуть в бланке анализа, а гинеколог дальше сам решит что делать с этой информацией и как лечить пациента.
Бордовой стрелкой напоминаю еще раз как выглядят нормальные ядра.
Как видите, вариантов поражения множество, но в любом из них становится сразу ясно, что до нормы тут далеко.
А тут вообще красивый комплекс попался. Некоторые ядра как будто закольцованы, со множеством лопастей, гигантские.
Да и общий фон не в порядке: большое количество лейкоцитов, говорящих о воспалении, скудная нездоровая флора...
Честно говоря уже не помню точно, но есть подозрение что многие из этих фото от одного пациента - уж больно общая картина схожая.
На этом откланиваюсь! Экскурсия в мир микроскопа подошла к концу. Надеюсь, объемом информации не слишком утомила.
Спасибо, что прочитали! За "пообщаться" приходите в комментарии.